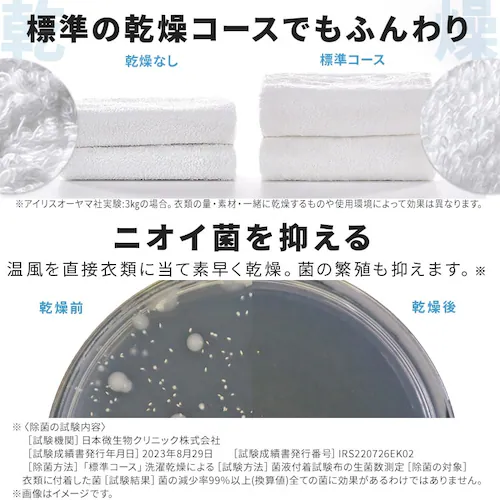
【訳あり】【設置無料】 洗濯乾燥機 ドラム式 8kg 乾燥4kg 左開き 洗剤自動投入 銀イオン除菌 温水洗浄 節水 お手入れ簡単 ファイブセンシング HDK842Z-W_6

獲得予定ポイント
- 通常ポイント内訳
- お買い物ポイント
- 1倍
- 合計
- 998ポイント
獲得予定ポイント
- 通常ポイント内訳
- お買い物ポイント
- 1倍
- 合計
- 998ポイント
商品をシェアする
【訳あり】【設置無料】 洗濯乾燥機 ドラム式 8kg 乾燥4kg 左開き 洗剤自動投入 銀イオン除菌 温水洗浄 節水 お手入れ簡単 ファイブセンシング HDK842Z-W
リンクをコピーしました。
【訳あり】【設置無料】 洗濯乾燥機 ドラム式 8kg 乾燥4kg 左開き 洗剤自動投入 銀イオン除菌 温水洗浄 節水 お手入れ簡単 ファイブセンシング HDK842Z-W
- OUTLET特価
- ¥99,800(税込) 送料無料
- 998ポイント
- (1倍)
お客様のご都合による返品は受け付けておりません。予めご了承くださいませ。
温水・Ag+、Wパワーで徹底除菌!
液体洗剤・柔軟剤“自動投入”で、入れ過ぎ、入れ忘れ解決!
ドラム式洗濯乾燥機 HDK842Z-W
[洗濯容量8kg/乾燥容量4kg]
イイことづくめのドラム式で、もっと洗濯がラクになる。
Point.1:洗剤自動投入/洗剤・柔軟剤自動投入で軽量いらず
洗剤や柔軟剤を必要な分だけ自動で計量。
入れすぎや入れ忘れを防ぎ、洗剤を入れる手間も省いてラクにする。
洗剤約850/柔軟剤約600mL。
一度設定したら、スタートを押すだけで洗濯完了!
(※液体合成洗剤、柔軟剤はそれぞれの容器に記載されている「使用量の目安表示」を事前にご確認のうえ、水30Lに対する使用量を設定する必要があります。)
\投入量も自分好みにカスタマイズ/
洗濯物や汚れに合わせて、ボタンで簡単調整。
手動投入もできるから、洗剤・柔軟剤の使い分けも簡単!
洗剤・柔軟剤のほか漂白剤の使用もできる。
Point.2:銀イオン(Ag+)×温水洗浄/Wパワーで洗浄力・除菌力UP
洗濯水、すすぎ水に銀イオンの効果をプラス。
洗うたび、衣類を除菌し、ニオイの発生も抑えます。
洗いあがりも部屋干しも、イヤなニオイから守る。
Point.3:ふんわり乾燥/「ふんわりシワ取りコース」を含めた、4つのモードを搭載
外気の取入れとセンサーの制御で、衣類にやさしい温風温度で乾燥。
乾燥でシワになりやすいシャツや綿のズボンは、アイロンの手間を減らしてくれる「ふんわりシワ取りコース」におまかせ。
\仕上がりに合わせて選べるコース/
・標準コース/洗濯量に合わせて乾燥時間を調整、しっかり乾かせる
・ふんわりシワ取りコース/シワを抑えながら、ふわっと仕上げてくれる
・最短30分から乾燥/仕上げ乾燥など、ちょっとだけ乾かしたいときに便利
・温水洗浄+乾燥/洗浄力の高い温水洗浄後と合わせてしっかり洗濯・乾燥
Point.4:温水洗浄/ニオイ・黄ばみを徹底除去
衣類や汚れに合わせた選べる温水で、洗浄効果を最大限に引き出す。
繊維の奥に染みついた黄ばみもスッキリ洗い流せます。
“衣類に合わせて選べる温水コース”
・肌着や白物に「60℃コース」/高温水で洗浄し、ニオイの原因徹底除菌!
・普段着やおしゃれ着に「40℃コース」/毎日のお洗濯で皮脂汚れ、ニオイ対策。
・ガンコな黄ばみに「40℃コース」+つけ置き約30分/染みついた黄ばみを温水+つけ置きでスッキリ!
“冬場のお洗濯に、洗い温度20℃設定”
洗剤が溶けやすくなる20℃設定で、高い洗浄力をキープ。
水温が下がりやすい、冬場のお洗濯におすすめです。
Point.5:高い節水性能
洗濯回数の多いご家庭におすすめ。
さらに、ドラム式洗濯機で採用している「たたき洗い」は衣類が傷みにくい。
Point.6:豊富なコース
100%乾燥する標準コースはもちろん、布団のような大物・おしゃれ着(手洗い)など、最適なコースを選べます。
【洗い方を「おこのみ設定」】
おこのみに合わせて設定を登録し、呼び出して運転できます。
【コースごとに最適な洗い方で洗浄力UP!】
コースごとに3パターンの洗い方(回転洗い、たたき洗い、ソフト洗い)の組み合わせを変更。
効果的に洗浄し、汚れを落とし
※製品は予告なく仕様を変更する場合がございます。あらかじめご了承ください。
●種類
ドラム式洗濯乾燥機、左開き
●定格電圧
AC100V
●定格周波数
50/60Hz共用
●定格入力
1000W
●消費電力
電動機:200W
温水用電熱装置:800W
温風用電熱装置:800W
●標準洗濯容量
8kg
●標準脱水容量
8kg
●標準使用水量
80L
●標準乾燥容量
4kg
●標準水量
30L
●防水レベル
IPX4
●外形寸法(cm)
幅約59.5×奥行約65.2×高さ約106.5
●質量
約81kg
●運転音
洗濯 約40dB / 脱水 約46dB / 乾燥 約44dB
●付属品
給水ホース、排水ホース、ホースクリップ、輸送用固定ねじ穴キャップ×4、スパナ(輸送用固定ねじ用、調節脚用)
| JAN |
4967576598460 [※種類]
|
|---|
レビューはまだ投稿されていません。お客様のレビューをお待ちしています
大変申し訳ありませんが、【配達時間指定】【代金引換でのお支払】は出来ません。ご了承ください。

残り 1個
※完売により、ご注文後にお断りする場合がございます。ご了承ください。